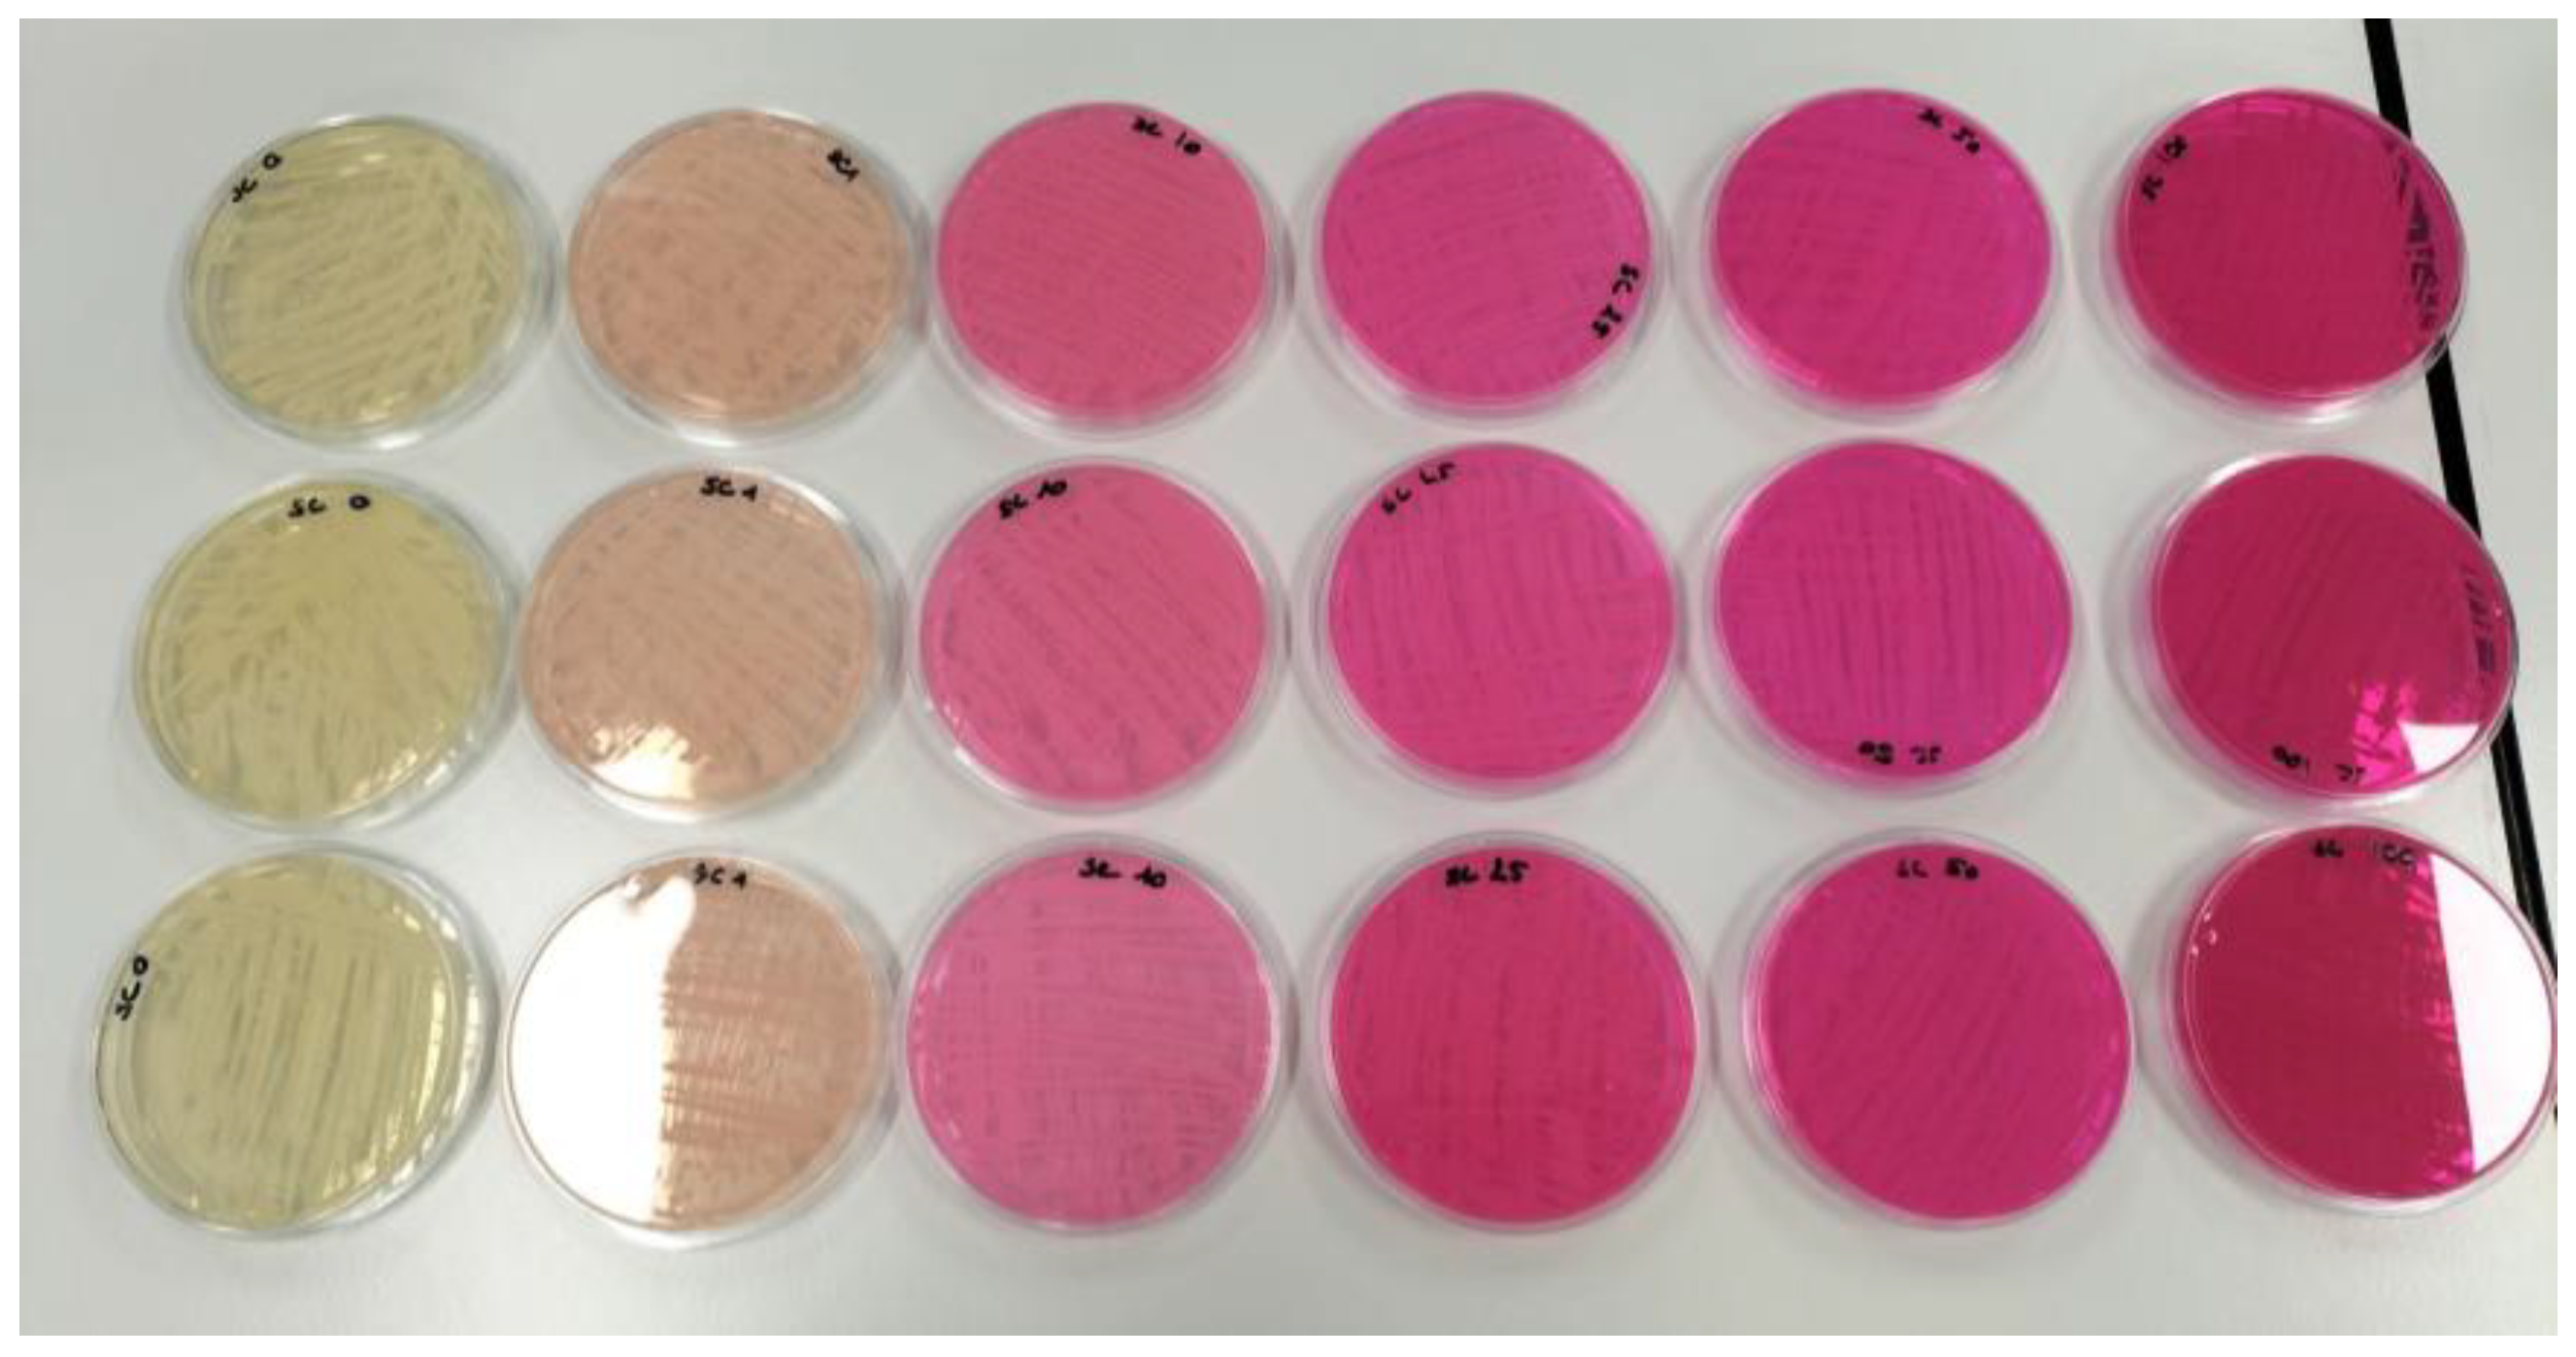
Processes 11 02671 g003 Processes 11 02671 g003
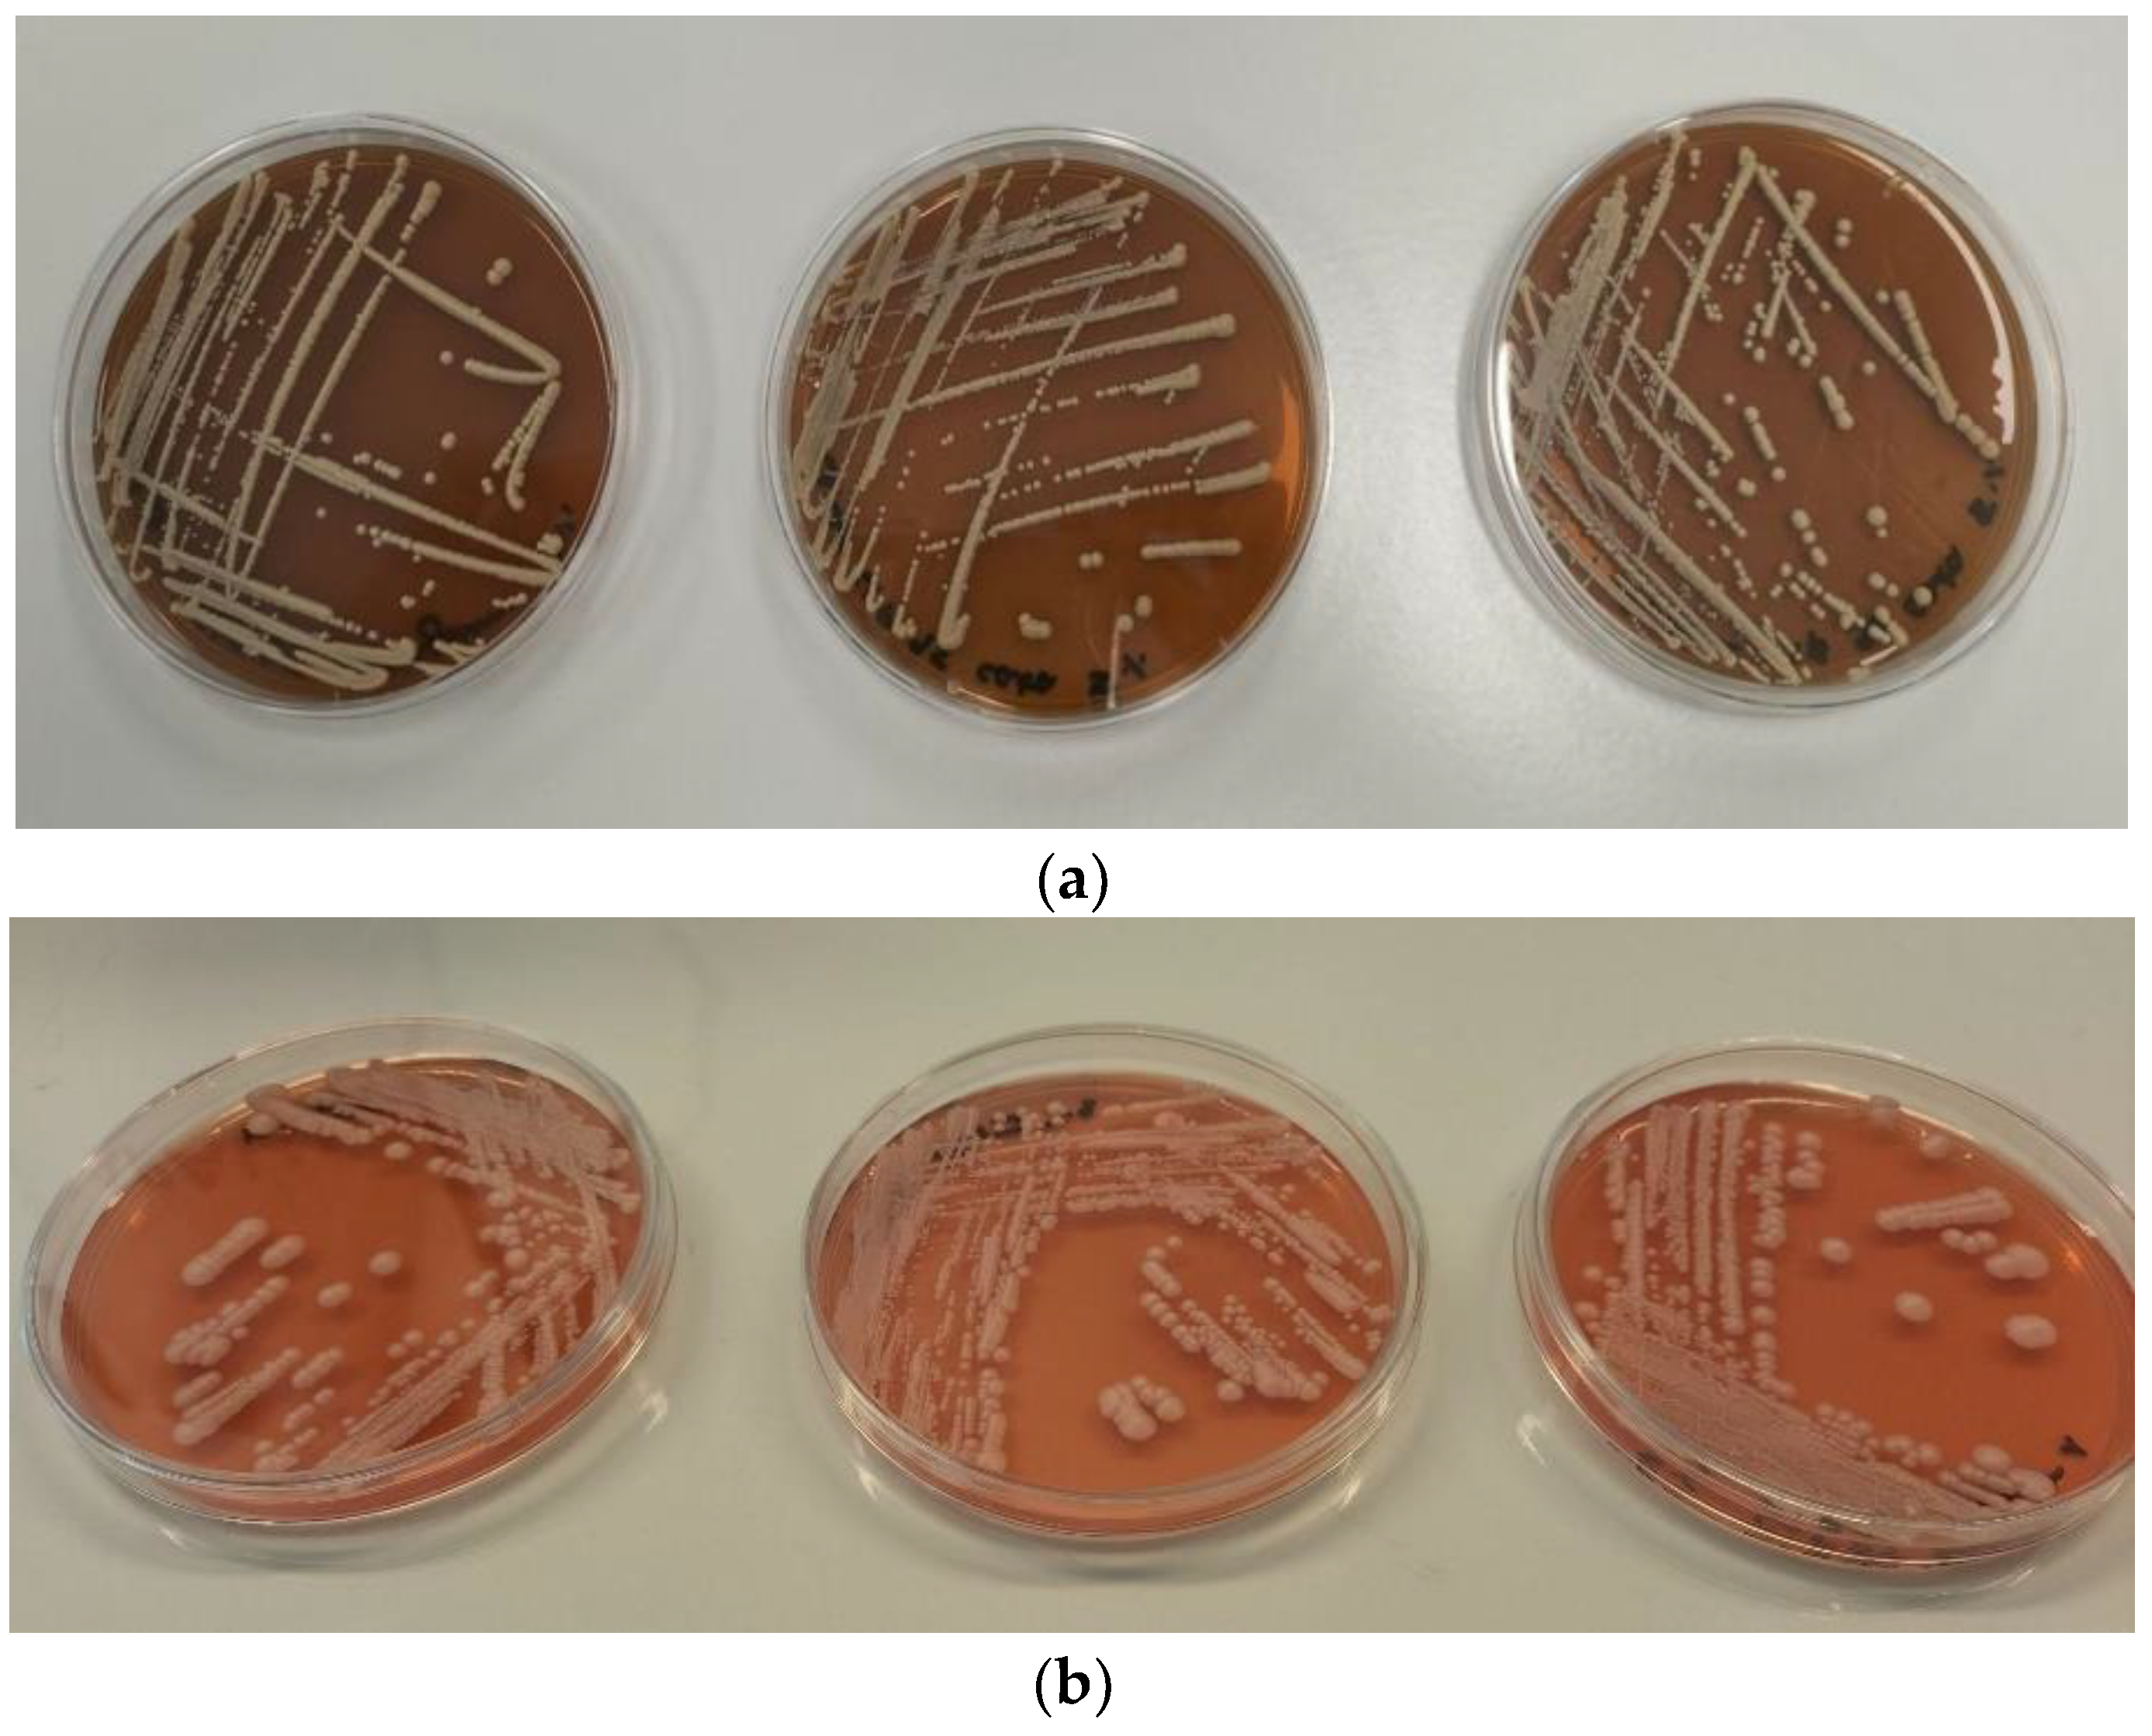
Processes 11 02671 g007 Processes 11 02671 g007

Comparative Study of Rhodamine B Treatment: Assessing of Efficiency Processes and Ecotoxicity of By-Products
Abstract
:1. Introduction
2. Materials and Methods
2.1. Rhodamine B
2.2. Microorganisms and Inoculum
2.3. Medium for Degradation and Biosorption Assays
2.4. Biosorption Assays
2.5. Biodegradation Assays
2.6. Bio-Acclimation Assays
2.7. Photocatalysis Assays
2.8. Toxicity Assays
2.8.1. Impact of Rhodamine B, Catalyst, and Treated Solutions on the Growth of S. cerevisiae
2.8.2. Impact of Rhodamine B, Catalyst, and Treated Solutions on the Germination of Watercress Seeds
2.8.3. Impact of Rhodamine B and Treated Solutions on the Immobilization of the Crustacean Daphnia magna
2.9. Analytical Methods
3. Results and Discussion
3.1. Biodegradation Tests on Rhodamine
3.1.1. Saccharomyces cerevisiae Growth in Presence of Rhodamine B
3.1.2. Biosorption
3.1.3. Biodegradation Study
3.1.4. Photocatalytic Study
3.1.5. Effect of Acclimation
3.2. Assessment of the Toxicity of RhB, the Catalyst, and Photocalysis By-Products
3.2.1. Effect on Saccharomyces cerevisiae Growth
3.2.2. Phytotoxicity Study
Daphnia magna Test
4. Conclusions
Author Contributions
Funding
Data Availability Statement
Acknowledgments
Conflicts of Interest
References
- Madhav, S.; Ahamad, A.; Singh, P.; Mishra, P.K. A Review of Textile Industry: Wet Processing, Environmental Impacts, and Effluent Treatment Methods. Environ. Qual. Manag. 2018, 27, 31–41. [Google Scholar] [CrossRef]
- Rasalingam, S.; Wu, C.-M.; Koodali, R.T. Modulation of Pore Sizes of Titanium Dioxide Photocatalysts by a Facile Template Free Hydrothermal Synthesis Method: Implications for Photocatalytic Degradation of Rhodamine B. ACS Appl. Mater. Interfaces 2015, 7, 4368–4380. [Google Scholar] [CrossRef] [PubMed]
- Lops, C.; Ancona, A.; Di Cesare, K.; Dumontel, B.; Garino, N.; Canavese, G.; Hérnandez, S.; Cauda, V. Sonophotocatalytic Degradation Mechanisms of Rhodamine B Dye via Radicals Generation by Micro- and Nano-Particles of ZnO. Appl. Catal. B Environ. 2019, 243, 629–640. [Google Scholar] [CrossRef] [PubMed]
- Merouani, S.; Hamdaoui, O.; Saoudi, F.; Chiha, M. Sonochemical Degradation of Rhodamine B in Aqueous Phase: Effects of Additives. Chem. Eng. J. 2010, 158, 550–557. [Google Scholar] [CrossRef]
- Senthil Rathi, B.; Senthil Kumar, P. Sustainable Approach on the Biodegradation of Azo Dyes: A Short Review. Curr. Opin. Green Sustain. Chem. 2022, 33, 100578. [Google Scholar] [CrossRef]
- Mahdi, C.; Pratama, C.A.; Pratiwi, H. Preventive Study Garlic Extract Water (Allium Sativum) Toward SGPT, SGOT, and the Description of Liver Histopathology on Rat (Rattus Norvegicus), Which Were Exposed by Rhodamine B. IOP Conf. Ser. Mater. Sci. Eng. 2019, 546, 062015. [Google Scholar] [CrossRef]
- Shanker, U.; Rani, M.; Jassal, V. Degradation of Hazardous Organic Dyes in Water by Nanomaterials. Environ. Chem. Lett. 2017, 15, 623–642. [Google Scholar] [CrossRef]
- Gonçalves, I.M.C.; Gomes, A.; Brás, R.; Ferra, M.I.A.; Amorim, M.T.P.; Porter, R.S. Biological Treatment of Effluent Containing Textile Dyes. Color. Technol. 2000, 116, 393–397. [Google Scholar] [CrossRef]
- Vatandoostarani, S.; Bagheri Lotfabad, T.; Heidarinasab, A.; Yaghmaei, S. Degradation of Azo Dye Methyl Red by Saccharomyces Cerevisiae ATCC 9763. Int. Biodeterior. Biodegrad. 2017, 125, 62–72. [Google Scholar] [CrossRef]
- Jia, C.; Kang, R.; Zhang, Y.; Cong, W.; Cai, Z. Synergic Treatment for Monosodium Glutamate Wastewater by Saccharomyces Cerevisiae and Coriolus Versicolor. Bioresour. Technol. 2007, 98, 967–970. [Google Scholar] [CrossRef]
- Jadhav, J.P.; Govindwar, S.P. Biotransformation of Malachite Green by Saccharomyces Cerevisiae MTCC 463. Yeast 2006, 23, 315–323. [Google Scholar] [CrossRef]
- Ikram, M.; Naeem, M.; Zahoor, M.; Hanafiah, M.M.; Oyekanmi, A.A.; Ullah, R.; Farraj, D.A.A.; Elshikh, M.S.; Zekker, I.; Gulfam, N. Biological Degradation of the Azo Dye Basic Orange 2 by Escherichia Coli: A Sustainable and Ecofriendly Approach for the Treatment of Textile Wastewater. Water 2022, 14, 2063. [Google Scholar] [CrossRef]
- He, X.-L.; Song, C.; Li, Y.-Y.; Wang, N.; Xu, L.; Han, X.; Wei, D.-S. Efficient Degradation of Azo Dyes by a Newly Isolated Fungus Trichoderma Tomentosum under Non-Sterile Conditions. Ecotoxicol. Environ. Saf. 2018, 150, 232–239. [Google Scholar] [CrossRef]
- Fan, J.; Chen, D.; Li, N.; Xu, Q.; Li, H.; He, J.; Lu, J. Adsorption and Biodegradation of Dye in Wastewater with Fe3O4@MIL-100 (Fe) Core–Shell Bio-Nanocomposites. Chemosphere 2018, 191, 315–323. [Google Scholar] [CrossRef] [PubMed]
- Xiao, W.; Garba, Z.N.; Sun, S.; Lawan, I.; Wang, L.; Lin, M.; Yuan, Z. Preparation and Evaluation of an Effective Activated Carbon from White Sugar for the Adsorption of Rhodamine B Dye. J. Clean. Prod. 2020, 253, 119989. [Google Scholar] [CrossRef]
- Pramugani, A.; Shimizu, T.; Goto, S.; Argo, T.; Soda, S. Decolorization and Biodegradability Enhancement of Synthetic Batik Wastewater Containing Reactive Black 5 and Reactive Orange 16 by Ozonation. Water 2022, 14, 3330. [Google Scholar] [CrossRef]
- Byrappa, K.; Subramani, A.K.; Ananda, S.; Rai, K.M.L.; Dinesh, R.; Yoshimura, M. Photocatalytic Degradation of Rhodamine B Dye Using Hydrothermally Synthesized ZnO. Bull. Mater. Sci. 2006, 29, 433–438. [Google Scholar] [CrossRef]
- Zeghioud, H.; Khellaf, N.; Amrane, A.; Djelal, H.; Bouhelassa, M.; Assadi, A.A.; Rtimi, S. Combining Photocatalytic Process and Biological Treatment for Reactive Green 12 Degradation: Optimization, Mineralization, and Phytotoxicity with Seed Germination. Environ. Sci. Pollut. Res. Int. 2021, 28, 12490–12499. [Google Scholar] [CrossRef]
- Cherif, S.; Bonnet, P.; Frezet, L.; Kane, A.; Assadi, A.A.; Trari, M.; Yazid, H.; Djelal, H. The Photocatalytic Degradation of a Binary Textile Dyes Mixture within a New Configuration of Loop Reactor Using ZnO Thin Film-Phytotoxicity Control. C. R. Chim. 2022, 25, 261–279. [Google Scholar] [CrossRef]
- Maruthupandy, M.; Muneeswaran, T.; Chackaravarthi, G.; Vennila, T.; Anand, M.; Cho, W.-S.; Quero, F. Synthesis of Chitosan/SnO2 Nanocomposites by Chemical Precipitation for Enhanced Visible Light Photocatalytic Degradation Efficiency of Congo Red and Rhodamine-B Dye Molecules. J. Photochem. Photobiol. Chem. 2022, 430, 113972. [Google Scholar] [CrossRef]
- Xu, D.; Ma, H. Degradation of Rhodamine B in Water by Ultrasound-Assisted TiO2 Photocatalysis. J. Clean. Prod. 2021, 313, 127758. [Google Scholar] [CrossRef]
- Cherif, S.; Djelal, H.; Firmin, S.; Bonnet, P.; Frezet, L.; Kane, A.; Amine Assadi, A.; Trari, M.; Yazid, H. The Impact of Material Design on the Photocatalytic Removal Efficiency and Toxicity of Two Textile Dyes. Environ. Sci. Pollut. Res. Int. 2022, 29, 66640–66658. [Google Scholar] [CrossRef] [PubMed]
- Chauhan, P.S.; Kumar, K.; Singh, K.; Bhattacharya, S. Fast Decolorization of Rhodamine-B Dye Using Novel V2O5-RGO Photocatalyst under Solar Irradiation. Synth. Met. 2022, 283, 116981. [Google Scholar] [CrossRef]
- Brosillon, S.; Djelal, H.; Merienne, N.; Amrane, A. Innovative Integrated Process for the Treatment of Azo Dyes: Coupling of Photocatalysis and Biological Treatment. Desalination 2008, 222, 331–339. [Google Scholar] [CrossRef]
- Sharma, G.; Dionysiou, D.D.; Sharma, S.; Kumar, A.; Al-Muhtaseb, A.H.; Naushad, M.; Stadler, F.J. Highly Efficient Sr/Ce/Activated Carbon Bimetallic Nanocomposite for Photoinduced Degradation of Rhodamine B. Catal. Today 2019, 335, 437–451. [Google Scholar] [CrossRef]
- Gičević, A.; Hindija, L.; Karačić, A. Toxicity of Azo Dyes in Pharmaceutical Industry; Springer International Publishing: Berlin/Heidelberg, Germany, 2020; Volume 73, pp. 581–587. [Google Scholar] [CrossRef]
- Reynoso, A.; Zeghioud, H.; Benitez-Rico, A.; Romero-Nuñez, A.; Djelal, H.; Chávez-Miyauchi, T.E.; Guillén-Cervantes, J.A. Photocatalytic Degradation of Rhodamine B with Cerium Doped Titania under Visible Light Led: Effect of Environmental Parameters and Response Surface Methodology Optimization. Available online: https://ssrn.com/abstract=4428997 (accessed on 30 August 2023).
- OECD Test Guidelines for Chemicals—OECD. Available online: https://www.oecd.org/chemicalsafety/testing/oecdguidelinesforthetestingofchemicals.htm (accessed on 1 June 2023).
- CEAEQ (CENTRE D’EXPERTISE EN ANALYSE ENVIRONNEMTALE DU QUEBEC). Détermination de La Toxicité: Létalité (CL50 48h) Chez La Daphnie Daphnia Magna. MA. 500–D.Mag. 1.1, Rév. 3; Ministère de l’Environnement et de La Lutte Contre Les Changements Climatiques Du Québec: Quebec, QC, Canada, 2021; 18p, Available online: https://www.ceaeq.gouv.qc.ca/methodes/pdf/MA500Dmag11.pdf (accessed on 1 June 2023).
- Ternes, T.A.; Herrmann, N.; Bonerz, M.; Thomas Knacker, T.; Siegrist, H.; Joss, A. Rapid method to measure the solid–water distribution coefficient (Kd) for pharmaceuticals and musk fragrances in sewage sludge. Water Res. 2004, 38, 4075–4084. [Google Scholar] [CrossRef]
- Kumar, A.; Chopra, J.; Singh, S.K.; Amir Khan, A.; Singh, R.N. Biodegradation of azo dyes by Bacillus subtilis ‘RA29’. Pharm. Lett. 2015, 7, 234–238. [Google Scholar]
- Saravanan, S.; Carolin, F.; Kumar, P.S.; Chitra, B.; Rangasamy, G. Biodegradation of textile dye Rhodamine-B by Brevundimonas diminuta and screening of their breakdown metabolites. Chemosphere 2022, 308, 136266. [Google Scholar] [CrossRef]
- Rahman, Q.I.; Ahmad, M.; Misra, S.K.; Lohani, M. Effective Photocatalytic Degradation of Rhodamine B Dye by ZnO Nanoparticles. Mater. Lett. 2013, 91, 170–174. [Google Scholar] [CrossRef]
- Gupta, V.K.; Saravanan, R.; Agarwal, S.; Gracia, F.; Khan, M.M.; Qin, J.; Mangalaraja, R.V. Degradation of azo dyes under different wavelengths of UV light with chitosan-SnO2 nanocomposites. J. Mol. Liq. 2017, 232, 423–430. [Google Scholar] [CrossRef]
- Waghmode, T.R.; Kurade, M.B.; Sapkal, R.T.; Bhosale, C.H.; Jeon, B.-H.; Govindwar, S.P. Sequential Photocatalysis and Biological Treatment for the Enhanced Degradation of the Persistent Azo Dye Methyl Red. J. Hazard. Mater. 2019, 371, 115–122. [Google Scholar] [CrossRef] [PubMed]
- Ajiboye, T.O.; Oyewo, O.A.; Onwudiwe, D.G. Adsorption and photocatalytic ermoval of rhodamine B from wastewater using carbon-based materials. FlatC 2021, 29, 100277. [Google Scholar] [CrossRef]
- Skjolding, L.M.; Jørgensen, L.v.G.; Dyhr, K.S.; Köppl, C.J.; McKnight, U.S.; Bauer-Gottwein, P.; Mayer, P.; Bjerg, P.L.; Baun, A. Assessing the Aquatic Toxicity and Environmental Safety of Tracer Compounds Rhodamine B and Rhodamine WT. Water Res. 2021, 197, 117109. [Google Scholar] [CrossRef] [PubMed]
- Balasurya, S.; Okla, M.K.; Mohebaldin, A.; AL-ghamdi, A.A.; Abdel-Maksoud, M.A.; Almunqedhi, B.; AbdElgawad, H.; Thomas, A.M.; Raju, L.; Khan, S.S. Self-assembling of 3D layered flower architecture of BiOI modified MgCr2O4 nanosphere for wider spectrum visible-light photocatalytic degradation of rhodamine B and malachite green: Mechanism, pathway, reactive sites and toxicity prediction. J. Environ. Manag. 2022, 308, 114614. [Google Scholar] [CrossRef] [PubMed]

| Physico-Chemical Properties | Rhodamine B |
|---|---|
| Molecular structure | ![]() |
| Molecular formula | C28H31ClN2O3 |
| Molecular weight (g mol−1) | 479.0 |
| Solubility (g L−1) at 25 °C | 8–10 |
| λmax (nm) | 554 |
| RhB (%) | TOC (%) | COD (%) | BOD5/COD | |
|---|---|---|---|---|
| 3 h | 42.5 | 4.9 | 0.0 | 0.20 |
| 6 h | 54.0 | 8.6 | 55.2 | 0.42 |
Disclaimer/Publisher’s Note: The statements, opinions and data contained in all publications are solely those of the individual author(s) and contributor(s) and not of MDPI and/or the editor(s). MDPI and/or the editor(s) disclaim responsibility for any injury to people or property resulting from any ideas, methods, instructions or products referred to in the content. |
© 2023 by the authors. Licensee MDPI, Basel, Switzerland. This article is an open access article distributed under the terms and conditions of the Creative Commons Attribution (CC BY) license (https://creativecommons.org/licenses/by/4.0/).
Share and Cite
Chadelaud, T.; Zeghioud, H.; Reynoso de la Garza, A.; Fuerte, O.; Benítez-Rico, A.; Revel, M.; Chávez-Miyauchi, T.E.; Djelal, H. Comparative Study of Rhodamine B Treatment: Assessing of Efficiency Processes and Ecotoxicity of By-Products. Processes 2023, 11, 2671. https://doi.org/10.3390/pr11092671
Chadelaud T, Zeghioud H, Reynoso de la Garza A, Fuerte O, Benítez-Rico A, Revel M, Chávez-Miyauchi TE, Djelal H. Comparative Study of Rhodamine B Treatment: Assessing of Efficiency Processes and Ecotoxicity of By-Products. Processes. 2023; 11(9):2671. https://doi.org/10.3390/pr11092671
Chicago/Turabian StyleChadelaud, Thomas, Hicham Zeghioud, Alonso Reynoso de la Garza, Omar Fuerte, Adriana Benítez-Rico, Messika Revel, Tomás E. Chávez-Miyauchi, and Hayet Djelal. 2023. "Comparative Study of Rhodamine B Treatment: Assessing of Efficiency Processes and Ecotoxicity of By-Products" Processes 11, no. 9: 2671. https://doi.org/10.3390/pr11092671
APA StyleChadelaud, T., Zeghioud, H., Reynoso de la Garza, A., Fuerte, O., Benítez-Rico, A., Revel, M., Chávez-Miyauchi, T. E., & Djelal, H. (2023). Comparative Study of Rhodamine B Treatment: Assessing of Efficiency Processes and Ecotoxicity of By-Products. Processes, 11(9), 2671. https://doi.org/10.3390/pr11092671


